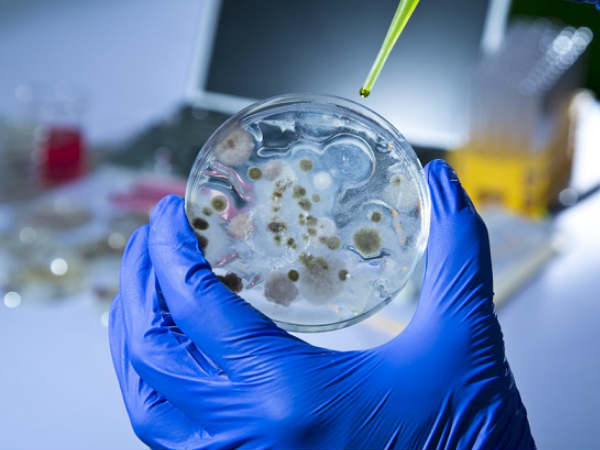
வளர்ச்சி

மனித இனத்திற்கு இப்படியொரு சோதனை வருமா? பதற வைக்கும் ஆய்வு முடிவு.!!
மனித இனம் உணவை தவிற எதை கொடுத்தாலும் போதும் என மன நிறைவு கொள்ளாது. இது எல்லாவற்றிற்கும் பொருந்தும். எல்லாவற்றிற்கும் எல்லை உண்டு, அளவிற்கு மிஞ்சினால் அமிர்தமும் நஞ்சு - இது அனைவருக்கும் தெரிந்தாலும் எல்லையில்லா உலகின் எல்லையை கண்டறிய மனித இனம் துடிப்பாய் இயங்கி வருகின்றது.

பணம்
துவக்கத்தில் தேவைகளை நிறைவேற்றி கொள்ள துடித்த இதயங்கள், இன்று அவசியமில்லா தேவைகளை உருவாக்கி அதன் மதிப்பை விளம்பரம் செய்து உயர்த்தி பணம் படைத்து வருகின்றது.

எச்சரிக்கை
இன்று சாதனையாய் தெரியும் பல மனித கண்டுபிடிப்புகள் பின்னாளில் மனித இனத்தையே அழிக்கும் என்ற எச்சரிக்கை ஒன்றை விடுத்துள்ளது சமீபத்திய ஆய்வு.
வளர்ச்சி
ரோபோட் மற்றும் அதிபயங்கர வைரஸ் கிருமிகள் மனித இனத்தை அழிப்பதில் பெரும் பங்கு வகிக்கும், இதனை அரசாங்கங்கள் முறையாக கவனிப்பதில்லை என இந்த ஆய்வில் தெரிவிக்கப்பட்டுள்ளது.

ஆபத்து
அதன் படி பருவநிலை மாற்றம், அணு ஆயுத போர், இயற்கை பேரழிவுகள், எரிமலை சீற்றங்கள் மற்றும் சிறுகோள் மூலம் மனித இனத்திற்கு பேராபத்து காத்திருப்பதாக ஆய்வாளர்கள் தெரிவித்துள்ளனர்.

உண்மை
திரைப்படங்களில் வருவதை போன்று இவை இருந்தாலும், இந்த ஆபத்துகள் நாம் நினைப்பதை விட மிகவும் கோரமானதாக இருக்கும் என தெரிவிக்கப்பட்டுள்ளது.

உலக பேரழவு ஆபத்துகள்
ஆக்ஸ்ஃபோர்டு பல்கலைக்கழக குழுவினர், குலோபல் சாலன்ஜஸ் பவுன்டேஷன் மற்றும் குலோபல் ப்ரியாரிட்டீஸ் ப்ராஜ்க்ட் போன்ற அமைப்புகள் இணைந்து உலக மக்கள் தொகையில் 10 சதவீதத்தை அழிக்க இருக்கும் பேரழிவுகள் சார்ந்த ஆய்வு அறிக்கை ஒன்றை வெளியிட்டுள்ளது.

தொடுவானம்
'தொடுவானத்தில் இருக்கும் சில விஷயங்கள் அடுத்த ஆண்டில் நடக்க வாய்ப்பில்லை என்றாலும், இவை நடந்தால் மிகவும் கோரமாக இருப்பதோடு ஒட்டுமொத்த உலகையே மாற்றியமைத்து விடும்' என குலோபல் ப்ரியாரிட்டீஸ் ப்ராஜக்ட் தலைவர் செபஸ்டியன் ஃபர்குஹர் தெரிவித்துள்ளார்.

எதிர்பார்ப்பு
இவை அனைத்தும் நம் உள்ளுணர்வு கொண்டு நினைப்பதை விட உண்மையில் நடக்கும் என வரலாறுகளை கொண்டே அறிந்து கொள்ள முடியும்.

மாற்றம்
தொழில்நுட்ப வழளிச்சி நம் வாழ்க்கையை மாற்றுவது போல இந்த ஆபத்துகளும் மாற்றம் கொண்டு வளர்கின்றது, ஆனால் இந்த ஆபத்துகளை எதிர்கொள்ள நாம் சிலவற்றை செய்ய முடியும்.

பேராபத்து
அடுத்த ஐந்து ஆண்டுகளில் சிறுகோள், எரிமலை வெடிப்பு மற்றும் இதர தெரியாத ஆபத்துகளால் மனித இனத்திற்கு அச்சுறுத்தலாக இருக்கும் என ஆய்வு அறிக்கையில் குறிப்பிடப்பட்டுள்ளது.

செயற்கை நுண்ணறிவு
நீண்ட காலத்தில் செயற்கை நுண்ணறிவு, பருவ நிலை மாற்றம், அணு ஆயுத போர் போன்றவை மனித இனத்திற்கு அச்சுறுத்தலாக இருக்கும்.

அச்சுறுத்தல்
மனித குலத்திற்கு மிகப்பெரிய அச்சுறுத்தலாக இயற்கை மற்றும் வடிவமைக்கப்பட்டுள்ள தொற்றுகள், அணு ஆயுத போர் போன்றவை இருக்கும் என இந்த ஆய்வில் தெரிவிக்கப்பட்டுள்ளது.

அணு ஆயுதம்
உலகில் அணு ஆயுதங்களை குறைக்க கோரப்பட்டிருந்தாலும், செயற்கை உயிரியல் துறையின் வளர்ச்சியானது பல்வேறு கொடிய கிறுமிகளின் வளர்ச்சிக்கு வழி செய்வதாக அமையும்.

ஆபத்து
பறவை காய்ச்சல் மாற்றங்களின் மூலம் பல லட்சம் மனித உயிர்களுக்கு ஆபத்து இருப்பதாக ஆய்வாளர்கள் தெரிவித்துள்ளனர்.

ஆதாரம்
தற்சமயம் எவ்வித ஆதாரமும் இல்லை என்றாலும், எதிர்காலத்தில் ஐஎஸ்ஐஎஸ் போன்ற அமைப்புகள் மக்களுக்கு கேடு விளைவிக்கும் கொடிய கிறுமிகளை உருவாக்கலாம் என செபஸ்டியன் ஃபர்குஹர் தெரிவித்துள்ளார்.

வலியுறுத்தல்
இந்த அறிக்கையில் சர்வதேச சமூகத்திற்கு தொற்றுகள் மற்றும் உடல்நல அமைப்புகள் சார்ந்த திட்டங்களை மேம்படுத்தவும், செயற்கை நுண்ணறிவு மற்றும் செயற்கை உயிரியலின் ஆபத்துகள் குறித்து விசாரனை மேற்கொள்ளவும், அணு ஆயுதங்களின் எண்ணிக்கையை குறைக்கவும் இந்த அறிக்கையில் வலியுறுத்தப்பட்டுள்ளது.

சீர்ப்படுத்துதல்
இப்பிரச்சனைகளை சீர்ப்படுத்த சர்வதேச ஒத்துழைப்பு மிகவும் அவசியம் என்றும் செபஸ்டியன் ஃபர்குஹர் தெரிவித்துள்ளார்.

ஆபத்து
இது போன்ற ஆபத்துகள் உலகளவில் நிச்சயம் பாதிக்கும் என்பதை அனைத்து உலக நாடுகளும் உணர வேண்டும் என்றும், இவை கொடிய கிறுமிகளை போன்று பூமியில் வாழும் மக்களை சமமாக பாதிக்கும் என்றும் அவர் தெரிவித்துள்ளார்.

மேலும் படிக்க
ரஷ்யா உருவாக்கிய நரகம் : 'டோபோல்-எம்'..!
புதிய உச்சத்தை எட்டும் பீதி : 'குறி' வைக்கப்படும் அமெரிக்கா..!

முகநூல்
இது போன்ற தொழில்நுட்பம் மற்றும் உலகின் வினோத தகவல்களை முகநூலில் படிக்க தமிழ் கிஸ்பாட் முகநூல் பக்கம்.



 Click it and Unblock the Notifications
Click it and Unblock the Notifications





























-1763362932432.svg)